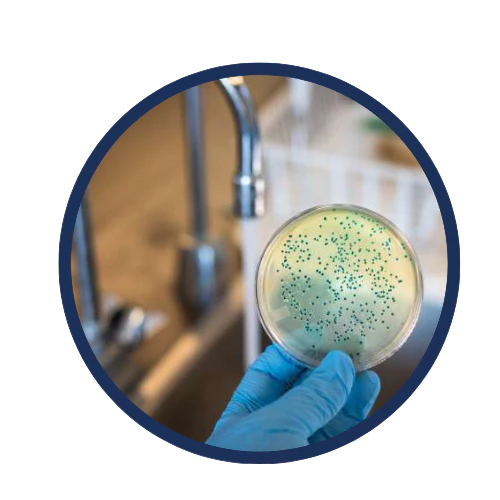

AIRSHIELD 2.0 (INCLUDES 1X ABSORPTION FILTER)
Optionen wählen
FLOWPURE FILTER REMOVES 100+ contaminants

CHLORINE

RUST

MICROPLASTICS

BACTERIA/VIRUSES

HEAVY METALS
PARASITES

ARSENIC

+ MANY MORE
what are the benefits of filtered water?

Immunity Function
Your immune system doesn't have to fight off these harmful substances meaning your body can function effectively leaving you and your family less prone to illness, keeping you stronger.

HEALTHY SKIN
Chemicals in unfiltered tap water strip your skin from natural oils, leading to dryness and irritation. It will worsen conditions like eczema/acne, leaving you itchy, and uncomfortable.w.

Increased Hydration
Hydration: Increases the best body functions, from promoting healthy skin to regulating body temperature. Hydration aids the transportation of nutrients and oxygen, giving you a healthier life.

With flowpure
- Filter out over 100+ contaminants
- Healthier Skin & Increased Energy
- Better taste and smell
- Major long-term savings
- Reduced chance of illness/disease

Without FlowPure
- 100+ water contaminants/ impurities
- Added chlorine, fluoride, heavy Metals
- High plastic waste from bottled water
- Higher chance of illness/ dehydration
- Basic/outdated or no filtration system
Independantly Tested
Tested and certified by independent laboratories across Europe to confirm health benefit and effectiveness.
Precise filtration
Our Flowpure filter stands out for its superior quality, featuring advanced filtration materials and a durable design that ensures effective removal of contaminants, delivering the safest and best-tasting water possible.
UNFILTERED TAP WATER
WHY YOU NEED FLOWPURE

3 Month Usage
Notice the multitude of impurities our advanced filter has captured. Drinking such contaminated water can lead to serious health risks for you and your family, potentially resulting in long-term health issues.
advanced technology

5 Different Built In Layers

Tap Fit Guarantee
Reducing Over 100 Impurities
OUR 5 STAGE FILTER COMPONENTS

Micropore Aluminium
Learn more
Diatom Natural Clay
Learn more
Activated Charcoal
Learn more
Micropore Aluminium
Learn more
PP cotton
Learn more


